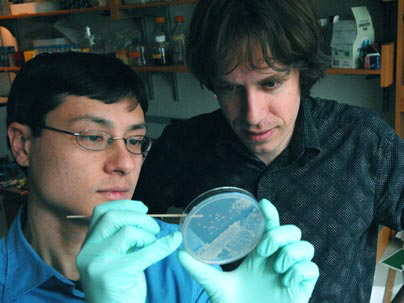

图片说明:MIT科学家培养酵母细胞进行蔗糖代谢实验。
(图片来源:Donna Coveney)
合作行为(cooperative behavior)是进化论中一个令人困惑的问题,它给种群内其它成员带来好处,但却会损害个体利益。生物学家对此迷惑不解——如果是最适者生存,那么有益于种群内所有成员的行为的基因就不该长期存在,合作行为应该灭绝。
美国麻省理工学院(MIT)科学家近日利用博弈论,解释了酵母规避这一问题的方法。研究显示,如果一个个体能够从合作行为中获取哪怕是微小的利益,那么即使周围的个体均不合作,它也能够生存下去。相关论文4月6日在线发表于《自然》(Nature)。
研究人员设计了一种实验装置,让酵母进行蔗糖代谢。蔗糖并非酵母的首选食物源,但在没有葡萄糖的情况下,它也会进行蔗糖代谢。不过,它们必须分泌一种蔗糖转化酶,帮助将蔗糖分解成单糖以便吸收。
问题在于,大量分解后的单糖也可被周围的其它酵母细胞利用。这种情况下,分泌转化酶的酵母称作合作者,不分泌、只消耗单糖的酵母称作欺诈者。
如果所有的单糖只是四下扩散,分泌转化酶的酵母没有优先使用权的话,那么更好的选择永远都是成为欺诈者,合作者将会灭绝。
研究实际发现,分泌转化酶的酵母对于它们制造的单糖拥有大约1%的优先使用权。这一获益超过了帮助别人所需的代价,使得它们能够成功地与欺诈者进行竞争。
此外,不论开始的酵母种群数量是多少,最后都会达到一种平衡状态,合作者和欺诈者同时存在。这类似于博弈论中的“铲雪博弈”——你和同伴开一辆车被雪堆挡住去路,每个人都可以选择下车铲雪或原位不动。一个人不铲雪,那么另一个人必须铲雪。
表面上看来,你最好的选择是待在温暖的车里,同伴去铲雪。但有时最坏的情况会发生,即你和同伴均不去铲雪,结果你们永远回不了家。因而,最好的策略是永远选择你对手策略的反面。
论文第一作者、MIT物理系的Jeff Gore表示,之前研究已经显示,在野生状态下,酵母携带的转化酶基因拷贝数存在不同。这种野外的遗传多样性,可能与实验室中观察到的合作者和欺诈者的长期共存相类似。(科学网 梅进/编译)

特别声明:本站注明稿件来源为其他媒体的文/图等稿件均为转载稿,本站转载出于非商业性的教育和科研之目的,并不意味着赞同其观点或证实其内容的真实性。如转载稿涉及版权等问题,请作者在两周内速来电或来函联系。
